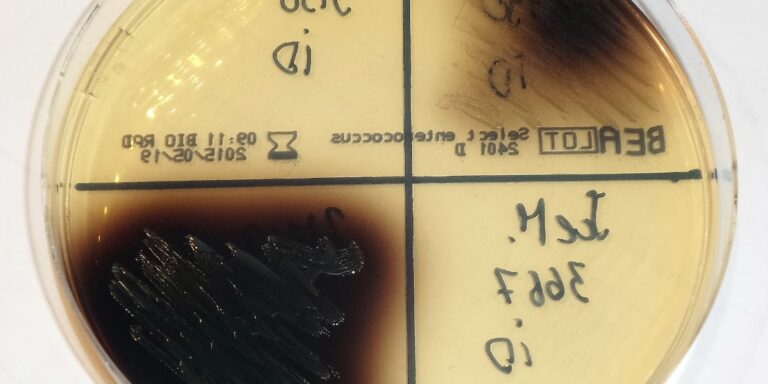
featured_image

This comprehensive post lists 36 Types of Microbial Growth, describing the defining conditions, typical organisms, and how each appears in the lab. Use this guide to quickly identify growth patterns—such as biofilms, pellicles, and colony morphologies—under different environmental and culture conditions. Ideal for students, lab technicians, and microbiology enthusiasts seeking a practical reference and visual cues for microbial growth classification.